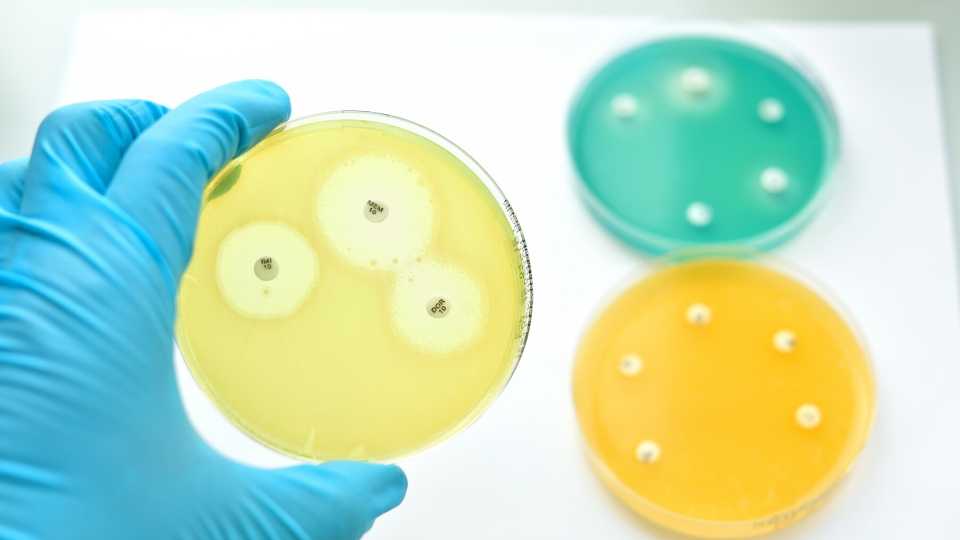

COLTEX PERU SAC empresa con más de 9 años de presencia en el mercado peruano especializada en la comercialización de insumos, especialidades y tecnología para el sector Textil, Cuero, Limpieza y Aseo, Papel, Minería y Plásticos.
Satisfacer oportunamente los requerimientos y necesidades de nuestro clientes basados en el soporte técnico, asesoría constante en la comercialización y desarrollo de productos de alta calidad, apostando asi por la innovación constante basándonos en la mejora continua de nuestros procesos que contribuyan además a la conservación del medio ambiente, contando para ello con tecnología apropiada y talento humano altamente calificado que brinda asistencia a las industrias que depositan su confianza en nosotros.
Al 2021 lograr ser una empresa reconocida en el mercado nacional e internacional en la importación, exportación, producción y comercialización de productos de alta calidad, superando las expectativas de nuestros clientes convirtiéndonos así en su mejor socio estratégico en los rubros Textil, Cuero, Limpieza y Aseo, Papel, Minería y Plásticos.

contabilidad@coltexperu.com.pe
contabilidad2@coltexperu.com.pe
Proporcionamos una visión actual y estratégica de los procesos humedos del sector textil, asesorándolo permanentemente.
Proporcionar los conocimientos técnicos y prácticos que le permita instalar un proceso eficiente. Mejorando el redimiento y consumo de recursos.
Proporcionar los conocimientos técnicos y prácticos que le permita solucionar dudas y/o dificultades tecnicas.
Desarrollo de color en diferentes sustratos, con la seleccion optima de la tricomía y buena reproducibilidad

Colorantes reactivos adecuados para aplicaciones de agotamiento de buenas propiedades .

Colorantes de alta concentración para tonos intensos con alto poder de fijación.

Colorantes de alta concentración para tonos intensos con alto poder de fijación.

Colorantes de alta brillantez y luminiscente.

Colorantes reactivos para tonos medios a intensos con buena reproductibilidad.

Colorantes de alta solidez a la luz y al cloro basados en química especializada base Flúor.

Colorantes reactivos calientes con buena solidez post mercerizado.

Colorantes dispersos de alta energía con todas las propiedades de solidez.

Colorantes dispersos de mediana energía con buenas propiedades de igualación.

Colorantes dispersos de baja energía con baja sublimación.

Colorantes dispersos de altas solideces al lavado y a la termomigración para polyester 100% y con elastano.

Colorantes dispersos fosforecentes adecuados para ropa de alta visibilidad y tonos brillantes.

Gama seleccionada de colorantes de complejos metálicos y de molienda ácida con buenas propiedades de igualación y migración.

Fresado de colorantes ácidos con buena solidez a la humedad, preferido para tonos oscuros en poliamida, lana y seda.

Colorantes ácidos de complejos metálicos con excelentes propiedades de solidez general recomendadas para la aplicación de lana.

Colorantes ácidos con alta solidez a la luz y lavado; aplicación recomendada para Poliamida, Lana, Nylon y Seda.

Gama exclusiva de colorantes sin metal para la coloración del cuero .

Gama exclusiva de tintes complejos de metal para coloración de cuero.

Colorantes hechos para tapiceria de muebles de cuero.

.

El Día Mundial de la Agricultura se celebra anualmente. El 9 de septiembre como homenaje a aquellas personas que dedican su vida al cultivo de la tierra con la finalidad de producir alimentos de la máxima calidad para el consumo de una sociedad creciente. Este día sirve para recordar los retos que debe afrontar el sector agrícola a escala global como necesaria adaptación al cambio climático ya los nuevos hábitos de consumo.
Read moreCOLTEX PERÚ ya es parte de la gran Ciudad Industrial Huachipa Este, El Principal Eje Industrial de Lima que te permite desarrollar todo el potencial que tu empresa necesita. 🔝🏗🏢 Bryson Hills Perú, promoviendo la Industria Ecoeficiente. #ElMomentoEsAhora #ExitoEmpresarial #CiudadIndustrial #ParqueIndustrial #HuachipaEste #BrysonHillsPeru Foto de Bryson Hills Perú SA en Bryson Hills Perú SA.
Read more
Producir una tela con propiedades virusidas, es decir, capaz de destruir o inactivar al virus que causa el COVID-19 podría ser posible, gracias a los avances de una investigación que vienen desarrollando los físicos e ingenieros textiles de la Universidad Nacional de Ingeniería (UNI). Este proyecto -ganador del concurso "Proyectos Especiales: Respuesta al COVID-19" del Concytec- es liderado por el físico José Luis Solis, y su equipo está integrado por los ingenieros textiles Esmeralda Román y Cleny Villalba; así como por la ingeniera química de la UNI Mónica Gómez. Ellos proponen usar este tipo de textil en la fabricación de la indumentaria médica, mascarillas, sábanas hospitalarias y toda prenda que sea utilizada por el personal sanitario que está expuesto al virus, y así darles mayor protección.
Read moreAv. Los Cisnes Mz E2 Lote 21 15457 Huachipa, Lima, Peru
ventas1@coltexperu.com.pe
+51 013532527